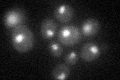
YKR029C
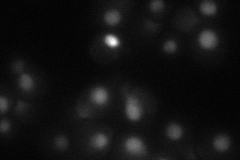
YKR029C
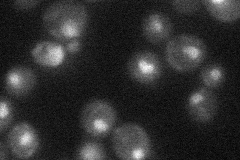
YKR029C
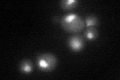
YKR029C
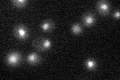
YKR029C

View description
Defining member of the SET3 histone deacetylase complex which is a meiosis-specific repressor of sporulation genes; necessary for efficient transcription by RNAPII; one of two yeast proteins that contains both SET and PHD domains
Localization:
Intensity:
Fold change:
Significance:
-
C’ GFP library in SD
nucleus25.27 -
N' NOP1pr-GFP in SD

nucleus0 -
N' TEF2pr-mCherry in SD
nucleus21.757 -
N' NATIVEpr-GFP in SD
nucleus29.0759 -
N' TEF2pr-VC and Cyto-VN in SD

#N/A0 -
C’ GFP library in SD+DTT
nucleus29.911.18No -
C’ GFP library in SD+H2O2

nucleus31.781.25No -
C’ GFP library in Starvation Media
nucleus25.381No -
C’ GFP library on the background of Pup2-DaMP

nucleus -
C’ GFP library on the background of CCT mutant

nucleus28.89251.14311No
